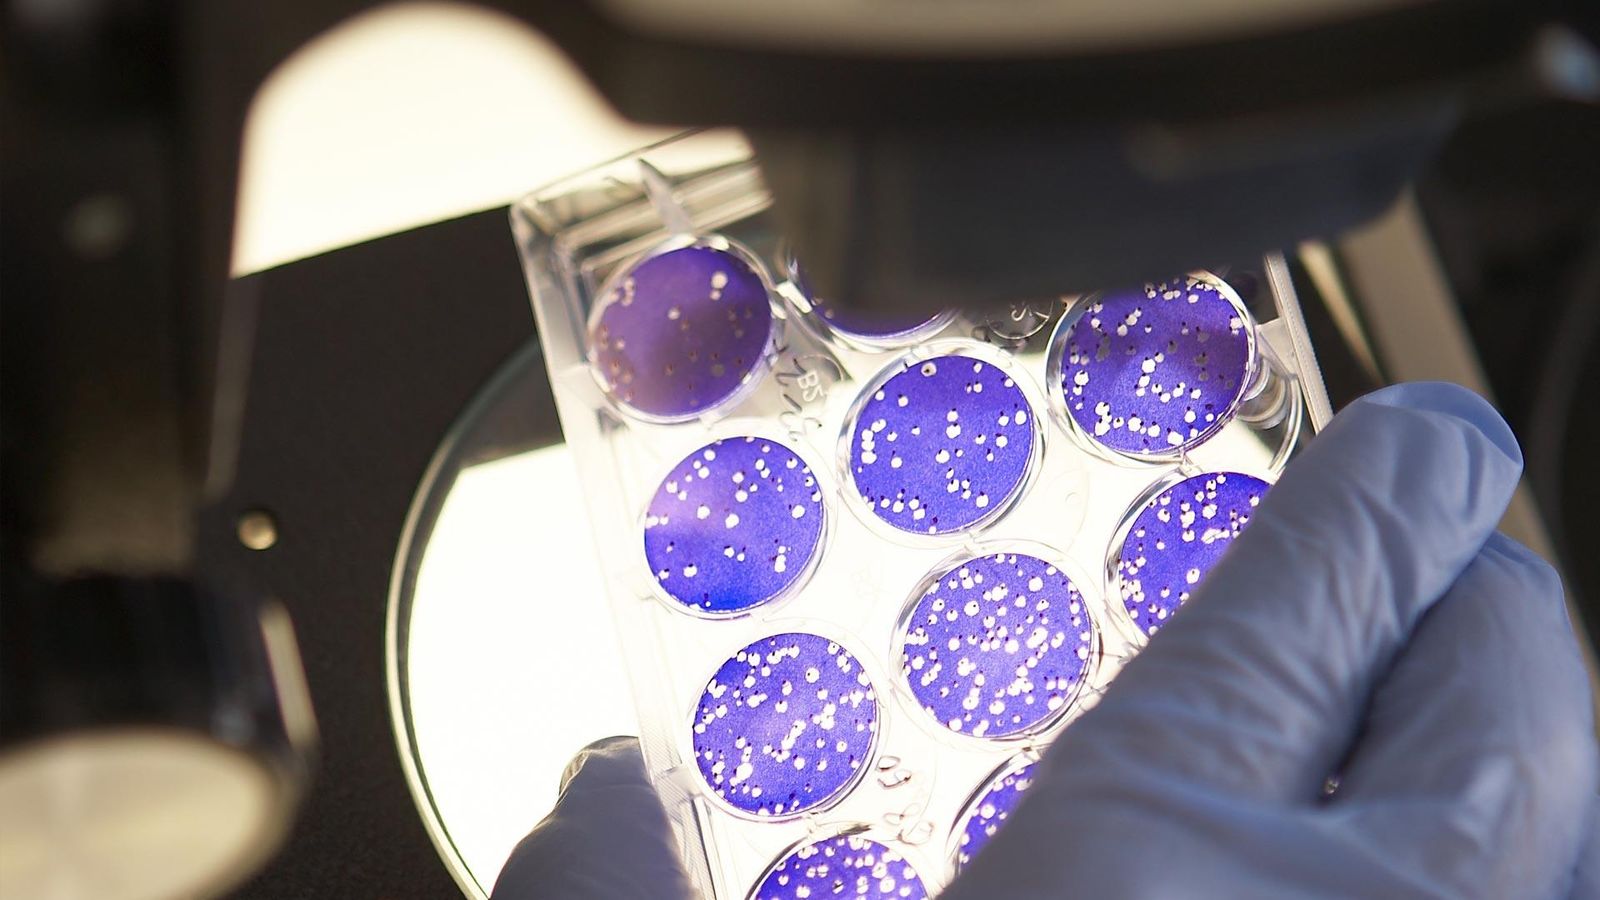

We chase the miracles of science to improve people's lives
Our progress brings us together and drives us to grow, learn and collectively push our limits. What do we mean by scientific miracles? For us, it means medical breakthroughs that lead to a significant improvement in patients' lives. In practice, it means that we focus our resources where the need is greatest and where the greatest potential to improve lives and protect public health exists.
Our Swedish office is located on Kungsholmen in Stockholm and employs around 150 people.
Sanofi in the world
+90 000
Mer än 90 000 anställda
90
Operating in more than 90 countries
100 years
Over 100 years of experience in innovation and research

Patient support: How to deal with a serious illness?
At Sanofi, our passion is to prevent, treat and cure diseases. We are driven to improve public health and find new solutions for patients by combining science with a deep understanding of patient needs.
Having a serious and long-term or chronic illness can change your life in many ways, requiring mental and physical capacity. Inspired by the needs of our patients, we have created these brochures in collaboration with psychologists Johanna Stenberg & Jan-Henry Stenberg from Finland in an effort to help people who have been affected by a serious illness.
The aim is to help patients gain perspective and understanding of their illness and inspire a way to cope with their new situation. Let's look at how to get out of the crisis caused by the disease!
Healthcare professionals can order the brochures in print via the form under:

Patient support: How to deal with a serious illness?
At Sanofi, our passion is to prevent, treat and cure diseases. We are driven to improve public health and find new solutions for patients by combining science with a deep understanding of patient needs.
Having a serious and long-term or chronic illness can change your life in many ways, requiring mental and physical capacity. Inspired by the needs of our patients, we have created these brochures in collaboration with psychologists Johanna Stenberg & Jan-Henry Stenberg from Finland in an effort to help people who have been affected by a serious illness.
The aim is to help patients gain perspective and understanding of their illness and inspire a way to cope with their new situation. Let's look at how to get out of the crisis caused by the disease!
Healthcare professionals can order the brochures in print via the form under:

Working with us
Forbes named us the second best employer in our industry in 2022. Start your career with us today.
Our therapeutic areas
Diabetes and cardiovascular diseases
Are you living with diabetes?
If you are living with diabetes, please visit our patient website insulin.se which is full of relevant information and support for those living with diabetes.
Immunology
Are you living with atopic eczema, asthma or nasal polyps?
If you are living with an atopic disease such as atopic dermatitis, asthma or nasal polyps, please visit our patient website atopiker.se which is full of relevant information and support for those living with these diseases.
Vaccines
Want to know more about vaccination?
Please visit our website vaccininfo.se which is full of relevant information for those who want to know more about flu vaccines, childhood vaccines, travel vaccines and much more.
Oncology Talks
Listen to our podcast "Immuno Oncology Talks".
Our oncology portfolio currently includes treatments in prostate cancer and blood cancer.
Neurology
Are you living with multiple sclerosis (MS)?
If you are living with multiple sclerosis (MS), please visit our patient website ms-guiden.se which is full of relevant information and support for those living with MS.
Rare diseases
Are you living with a rare disease?
If you are living with a rare disease such as Fabry disease, Gaucher disease, Pompe disease, MPS1, TTP or thyroid cancer, please visit our patient website rarediseases.com which is full of relevant information and support for those living with these diseases.
Patient support: How to deal with a serious illness?
At Sanofi, our passion is to prevent, treat and cure diseases. We are driven to improve public health and find new solutions for patients by combining science with a deep understanding of patient needs.
Having a serious and long-term or chronic illness can change your life in many ways, requiring mental and physical capacity. Inspired by the needs of our patients, we have created these brochures in collaboration with psychologists Johanna Stenberg & Jan-Henry Stenberg from Finland in an effort to help people who have been affected by a serious illness.
The aim is to help patients gain perspective and understanding of their illness and inspire a way to cope with their new situation. Let's look at how to get out of the crisis caused by the disease!
Healthcare professionals can order the brochures in print via the form under:
Patient support: How to deal with a serious illness?
At Sanofi, our passion is to prevent, treat and cure diseases. We are driven to improve public health and find new solutions for patients by combining science with a deep understanding of patient needs.
Having a serious and long-term or chronic illness can change your life in many ways, requiring mental and physical capacity. Inspired by the needs of our patients, we have created these brochures in collaboration with psychologists Johanna Stenberg & Jan-Henry Stenberg from Finland in an effort to help people who have been affected by a serious illness.
The aim is to help patients gain perspective and understanding of their illness and inspire a way to cope with their new situation. Let's look at how to get out of the crisis caused by the disease!
Healthcare professionals can order the brochures in print via the form under:
Serious illness diagnosis - how do I proceed now?
What happens when you get a serious illness and how do you deal with a life-changing diagnosis?
On World Health Day on 7 April, we organized a Facebook live stream on coping with a serious illness, where a psychologist answered questions on this topic. We also discussed how family members can help in such a difficult situation.



